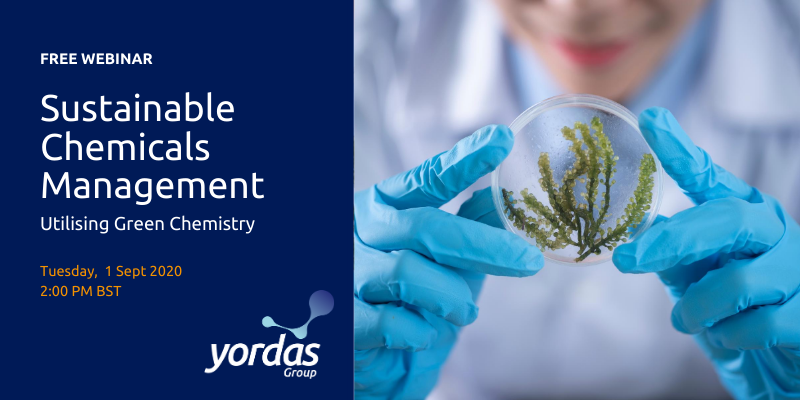

ABOUT US
The Chemical Industry Journal is designed to generate collaboration, sustainable growth and competitive advantage within the Chemicals Industry, while building links with industries such as medical, construction, transport, leisure and government.
Contact us: editorial@chemicalindustryjournal.co.uk
© Distinctive Media Group